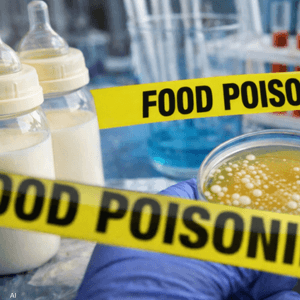
النتائج ليست قاطعة وإن التحقيق مستمر

فرنسا.. إجراء احترازي جديد بعد أزمة "حليب الأطفال الملوث"
14:58 - 31 يناير 2026
خفضت فرنسا الحد الأقصى المسموح به من مادة "السيروليد" السامة في حليب الأطفال، بهدف تعزيز إجراءات الحماية، حسبما قالت وزارة الزراعة، السبت.
وتأتي الخطوة بعد أن أمرت عدة شركات كبرى بسحب منتجات من أسواق في شتى أنحاء العالم، خوفا من تلوثها.
وتم اكتشاف مادة السيروليد، التي يمكن أن تسبب الغثيان والقيء، في مكونات يوردها مصنع في الصين إلى عدد كبير من شركات صناعة حليب الأطفال، مثل "نستله" و"دانون" و"لاكتاليس"، مما أدى إلى سحب منتجات في عشرات البلدان وأثار مخاوف الآباء.
وقالت الوزارة في بيان إن الحد الأقصى الجديد سيكون 0.014 ميكروغرام من "السيروليد" لكل كيلوغرام من كتلة الجسم، مقارنة بـ0.03 ميكروغرام لكل كيلوغرام سابقا.
وذكرت الوزارة أن الخطوة تأتي في أعقاب اجتماع للاتحاد الأوروبي في 28 يناير، وتتماشى مع التوجيهات المحدثة من الهيئة الأوروبية لسلامة الأغذية التي ستصدر الإثنين.
وأضافت الوزارة أن الحد الأقصى الجديد والمخفض من المادة سيؤدي على الأرجح إلى مزيد من عمليات سحب المنتجات في فرنسا في الأيام المقبلة.
وقالت السلطات الفرنسية في 23 يناير الجاري، إنها تحقق في وجود صلة بين وفاة رضيعين ومنتجات حليب أطفال تم سحبها من الأسواق.
والخميس قالت منظمة "فود ووتش" المعنية بحماية المستهلكين، إنها قدمت شكوى جنائية في باريس نيابة عن 8 عائلات تقول إن أطفالها أصيبوا بالإعياء بعد تناول حليب أطفال ملوث، متهمة الشركات بأنها انتظرت وقتا أطول من اللازم قبل تحذير الجمهور.